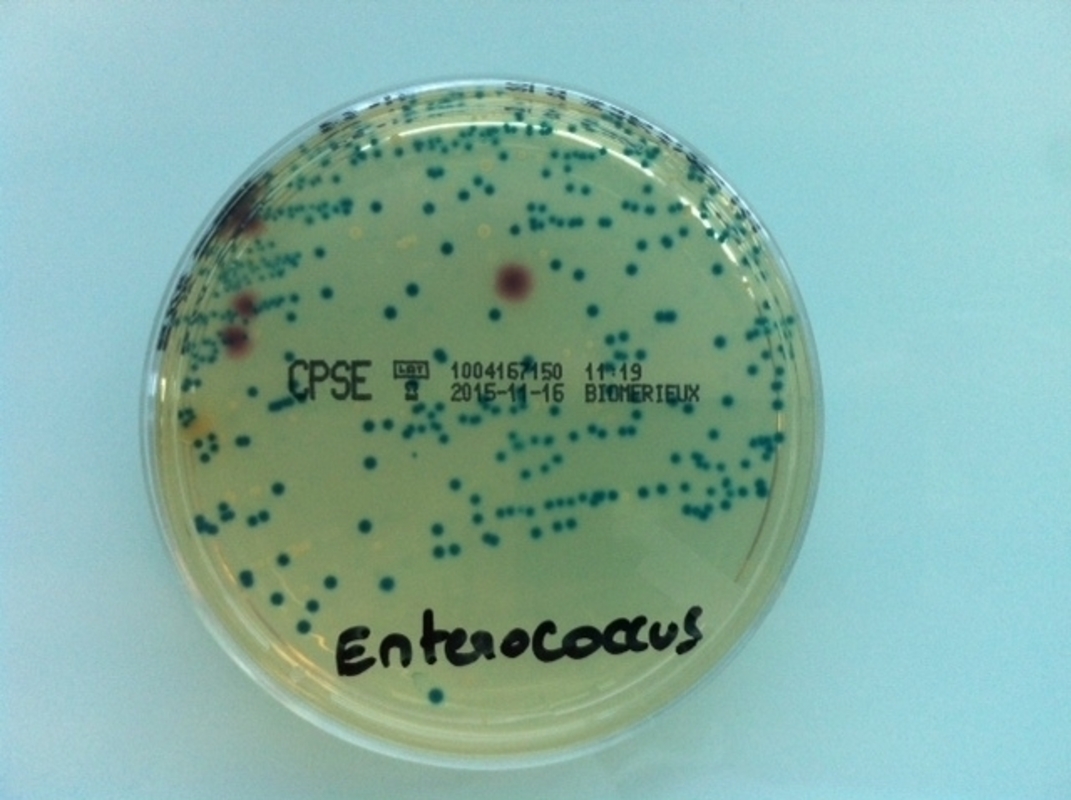
Воздействие одного антибиотика приводит к приобретению резистентности к другому антибиотику через Quorum Sensing механизмы

Энтерококки являются нозокомиальными бактериями с множественной лекарственной резистентностью.
Оппортунистический патоген E. faecalis вызывает инфекции мочевыводящих путей и эндокардит. Как правило, инфекции возникают у пациентов с ослабленной иммунной системой и получивших несколько курсов антибиотиков. Вскоре после первого выделения ванкомицин-резистентных энтерококков (VRE) в 1988 году они распространились с непредвиденной быстротой. Энтерококки умеют распространять гены, кодирующие лекарственную резистентность (Arias and Murray, 2009). У E. faecalis индуцируемая феромонами конъюгация является высокоэффективным процессом передачи резистентности к антибиотикам и вирулентности (Hirt et al., 2018).
VRE энтерококки постепенно становятся серьезной медицинской проблемой. Хотя клиники начали сокращать назначение ванкомицина, резистентность к ванкомицину не удается сдержать. Мы обнаружили, что передача резистентности к ванкомицину у Enterococcus faecalis увеличилась более чем в 30 раз после лечения стрептомицином. Примечательно, что лечение одним антибиотиком вызывало у бактерий резистентность к другому.
Ответ был еще сильнее в хорошо изученной плазмиде pCF10, и количество трансконъюгантов увеличилось примерно в 100 000 раз. Мы протестировали четыре различных антибиотика, и все они индуцировали конъюгальный ответ. С помощью математической модели, основанной на регуляции генов, мы нашли правдоподобное объяснение. Изменение плотности клеток вызывает конъюгацию благодаря quorum sensing. Более того, мы искали общее объяснение и обнаружили аналогичную стратегию у Bacillus subtilis.
Энтерококки печально известны как возбудители нозокомиальных инфекций и настоящее исследование показало, что применение одного из распространенных антибиотиков привело к постепенному распространению плазмид, кодирующих резистентность к другим антибиотикам, включая ванкомицин. Отметим, что не только донорные клетки E. faecalis способны ощущать собственную плотность с помощью сигнала quorum-sensing, но и доноры Bacillus subtilis (Itaya et al., 2006) выделяют сигнал quorum-sensing phr*LS20 для неактивной конъюгации (Singh et al., 2013). Такая стратегия quorum-sensing не является уникальной для E. faecalis.
Результаты настоящего исследования свидетельствуют о том, что не следует злоупотреблять даже распространенными антибиотиками.